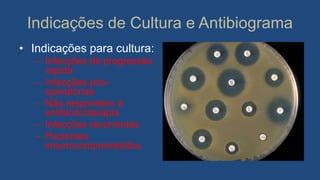
Indicações de Cultura e Antibiograma
• Indicações para cultura:
– Infecções de progressão
rápida
– Infecções pós-
operatórias
– Não respondem á
antibioticoterapia
– Infecções recorrentes
– Pacientes
imiunocomprometidos

O documento discute infecções odontogênicas, abordando tópicos como etiologia, microbiologia, evolução, vias de disseminação, tratamento e prognóstico. Detalha os tipos de bactérias envolvidas, como as infecções se desenvolvem e se espalham através dos tecidos faciais, e os métodos de diagnóstico, drenagem e terapia antibiótica para o tratamento.